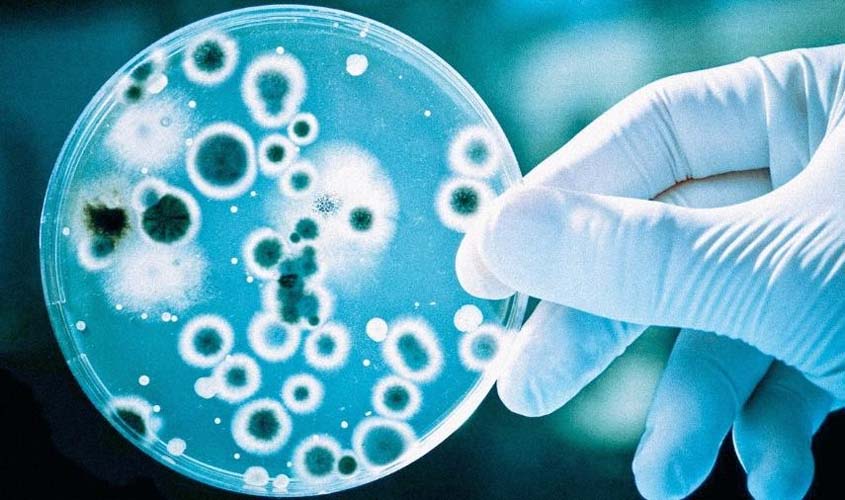
No Brasil, o registro de casos de superbactérias vem acendendo alerta entre as autoridades da Saúde

Prazo para participar do edital do Fundo Municipal dos Direitos da Criança e do Adolescente encerra nesta sexta-feira (21)
Para participar do edital, entidades governamentais e não-governamentais, podem apresentar projetos conforme os eixos estipulados
Claudi Rocha chama a atenção das entidades governamentais e não-governamentais interessadas
O secretário municipal da Assistência Social e da Família (Semasf), Claudi Rocha, membro do Conselho Municipal dos Direitos da Criança e do Adolescente (CMDCA), chama a atenção das entidades governamentais e não-governamentais interessadas, que o prazo para apresentação de projetos para participar do edital do Fundo Municipal dos Direitos da Criança e do Adolescente, no valor de R$ 2.250.908,12, se encerra na próxima sexta-feira (21).
O edital foi aprovado por meio da Resolução 240/2023 do Conselho Municipal dos Direitos da Criança e do Adolescente, publicada no Diário Oficial dos Municípios do Estado de Rondônia, nº 3501, de 23/06/2023. Para participar do edital, entidades governamentais e não-governamentais, podem apresentar projetos conforme os eixos:
Eixo I - Apoiar projetos relacionados à convivência familiar e comunitária de crianças e adolescentes, valor total R$ 1.762.908,12. Aprovar dois projetos, sendo o valor de referência R$ 350 mil; dois projetos de R$ 200 mil; e quatro projetos no valor de R$ 165,727,03.
Eixo II - Apoiar projetos de fortalecimento do sistema socioeducativo municipal, no valor total de R$ 193 mil. Aprovar dois projetos, sendo o valor de referência R$ 96.050,00
Eixo III - Apoiar Implementação de ações voltadas à proteção integral de crianças e adolescentes, valor total de R$ 110 mil. Aprovar um projeto de referência de R$ R$ 110 mil.
Eixo IV - Apoiar projetos de fortalecimento às estratégias de enfrentamento ao trabalho infantil e proteção atividade ao adolescente aprendiz, valor total R$ 185 mil. Apoiar dois projetos, sendo no valor de referência R$ 92.050,00.
O prazo para apresentação de projetos e participar do edital do CMDCA também está estabelecido no cronograma do edital. Os projetos devem ser entregues no Conselho Municipal de Direitos da Criança e do Adolescente (CMDCA), à av. Guanabara, 965, bairro Nossa Senhora das Graças - Casa dos Conselhos Municipais, das 8h às 14h. Informações: e-mail [email protected], telefone (69) 98473 4098.
Com economia do estado em alta, Casa do Construtor busca potenciais franqueados em Rondônia
Neste primeiro momento, os municípios-alvo são Ji-Paraná e Ariquemes
No Brasil, o registro de casos de superbactérias vem acendendo alerta entre as autoridades da Saúde
Segundo o estudo, a hipótese mais provável para o aumento da superbactéria é a superlotação de hospitais, a falta de preparo dos profissionais da saúde e o uso descontrolado de antibióticos
Simero promove palestra sobre a proposta da reforma tributária em palestra com Emílio Albuquerque
Durante o evento, a presidente do Simero, Dra. Flávia Lenzi, enfatizou a importância de uma reforma tributária adequada para o Brasil

Comentários
Seja o primeiro a comentar
Envie Comentários utilizando sua conta do Facebook